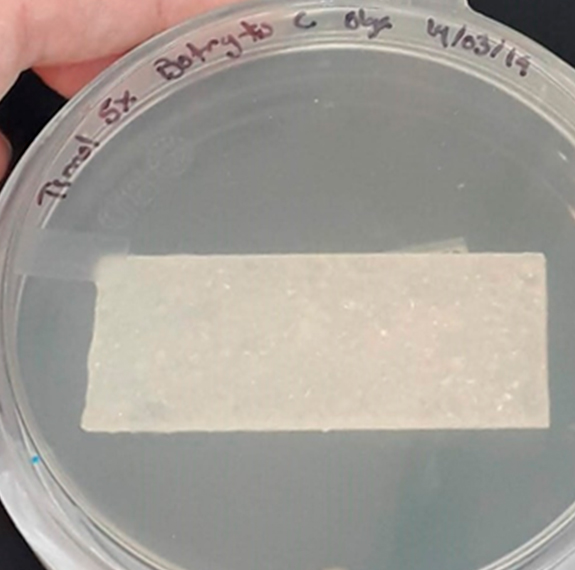
Universidad Panamericana logra su quinta patente
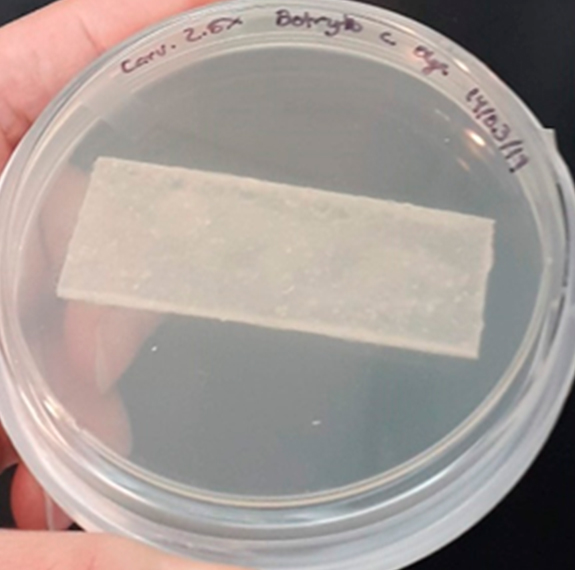
Universidad Panamericana logra su quinta patente

Con orgullo anunciamos que la Universidad Panamericana ha sido otorgada su quinta patente, marcando un hito significativo en nuestra trayectoria de investigación y desarrollo. El Instituto Mexicano de la Propiedad Industrial (IMPI) ha reconocido nuestra innovación en el campo de los materiales biodegradables, otorgando la patente del “Proceso de inyección de matriz polimérica de ácido poliláctico”.

Este logro representa un avance técnico, que habilita una solución efectiva a los desafíos de sostenibilidad en la industria del empaque. La patente resuelve la necesidad de desarrollar empaques plásticos activos biodegradables que, a través de procesos de extrusión e inyección, permiten la liberación controlada de antimicrobianos y antifúngicos.

El equipo de inventores del campus Guadalajara, liderado por Friné Velázquez Contreras, de la Escuela de Hospitalidad y Héctor Rubén Acevedo Parra, de la Facultad de Ingenierías son un testimonio del compromiso de la Universidad Panamericana con la innovación aplicada y la investigación colaborativa con la industria.
Este proyecto se enmarca dentro de la estrategia de Innovación y Transferencia de la Universidad, dirigida por la Vicerrectoría General de Investigación. El Dr. Juan Alberto González Piñón, director corporativo, destacó el papel fundamental del Centro de Gestión de Propiedad Intelectual de la Panamericana, cuyo propósito es apoyar y facilitar los procesos de gestión y protección de la propiedad intelectual de las invenciones resultantes de la investigación científica realizada por nuestros investigadores. Seguimos comprometidos con el impulso del talento universitario y la creación de soluciones que no solo promueven el conocimiento científico, sino que también contribuyen significativamente a la resolución de problemas sociales relevantes.

Celebramos este nuevo éxito y reafirmamos nuestro liderazgo en la investigación e innovación, fortaleciendo el impacto de la Universidad Panamericana a nivel nacional e internacional en la ciencia y tecnología.




